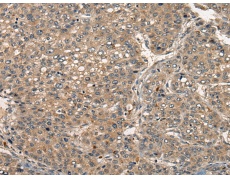
一抗

|
Background: |
The protein encoded by this gene is a cytokine that belongs to the tumor necrosis factor (TNF) ligand family. This cytokine is a ligand for TNFRSF8/CD30, which is a cell surface antigen and a marker for Hodgkin lymphoma and related hematologic malignancies. The engagement of this cytokine expressed on B cell surface plays an inhibitory role in modulating Ig class switch. This cytokine was shown to enhance cell proliferation of some lymphoma cell lines, while to induce cell death and reduce cell proliferation of other lymphoma cell lines. The pleiotropic biologic activities of this cytokine on different CD30+ lymphoma cell lines may play a pathophysiologic role in Hodgkin's and some non-Hodgkin's lymphomas. Two transcript variants encoding different isoforms have been found for this gene. |
|
Applications: |
ELISA, IHC |
|
Name of antibody: |
TNFSF8 |
|
Immunogen: |
Synthetic peptide of human TNFSF8 |
|
Full name: |
tumor necrosis factor superfamily member 8 |
|
Synonyms: |
CD153; CD30L; CD30LG; TNLG3A |
|
SwissProt: |
P32971 |
|
ELISA Recommended dilution: |
5000-10000 |
|
IHC positive control: |
Human liver cancer |
|
IHC Recommend dilution: |
25-10 |

 購物車
購物車 幫助
幫助
 021-54845833/15800441009
021-54845833/15800441009